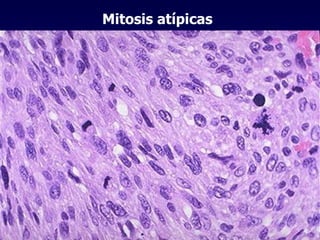
Mitosis atípicas

El documento define las neoplasias malignas y describe sus características biológicas a nivel celular, tisular y clínico. Explica que son crecimientos patológicos autónomos e irreversibles cuyas evolución natural es incompatible con la vida. Describe los criterios de malignidad como mitosis anormales, invasión tisular, metástasis y la capacidad de producir efectos sistémicos en el organismo. También analiza los mecanismos moleculares como la sobreexpresión de oncogenes que conducen a la autos